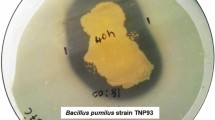

Abstract
This study aimed to characterize a lipase that is highly active and stable under typical washing conditions for use as a detergent ingredient by investigating the effects of various boron compounds on lipase stabilization under different conditions. In addition, the antimicrobial activity of the boron compounds used in enzyme stabilization was examined in order to obtain an effective antimicrobial detergent. A lipase-producing bacterium was isolated from kitchen wastewater samples using Rhodamine-B Agar medium and identified as Pseudomonas aeruginosa based on 16S rDNA sequence analysis. The ES3 lipase obtained from P. aeruginosa was purified, and the purified enzyme was found to have a molecular mass of 40 kDa. The enzyme showed optimal activity at pH 9.0–10.0 and 40 °C and remained stable in the presence of various metal ions, surfactants and oxidizing agents. Moreover, the pH stability and thermostability of the enzyme was improved by the addition of boron compounds, which, when used as stabilizers in the incubation media, also increased the stability of the enzyme towards commercial detergents. Furthermore, the enzyme displayed properties comparable with the commercial product Lipolase®, which has shown excellent stability towards various commercial detergents. Finally, boron compounds used to stabilize the lipase were found to possess antimicrobial properties, suggesting that detergents incorporating these compounds will also exhibit antimicrobial activity when washing clothes and dishes.
Similar content being viewed by others
Explore related subjects
Discover the latest articles, news and stories from top researchers in related subjects.Avoid common mistakes on your manuscript.
Introduction
Lipases catalyze the hydrolysis of long chain hydrophobic triglycerides to more hydrophilic monoglycerides, diglycerides, free fatty acids and glycerol [1, 2]. For this reason, over the years, lipases have been used as ingredients in household and industrial laundry and household dishwasher detergents [3] to aid in the removal of dirt-containing oils and fats of vegetable and animal origin [4]. However, lipase activity is greatly reduced by the surfactants, oxidizing agents and other enzymes present in detergents as well as by high pH environments, high washing temperatures and the presence of calcium chloride or chlorine in tap water [4–6].
Current research into the use of lipases in detergent formulations is focused primarily on the development of new enzymes that can exhibit greater resistance and better performance under actual washing conditions [6, 7]. In order to obtain a lipase that retains a high level of activity as a detergent additive, studies have examined both natural sources of enzymes as well as techniques for lipase stabilization. Isolation and screening of microorganisms from naturally occurring alkaline habitats or from alkaline wastewaters are expected to provide new strains of bacteria capable of producing enzymes that are active and stable under highly alkaline conditions and show resistance to the chemical denaturants present in detergents [8, 9]. While commercially available lipases have been engineered to further enhance enzyme stability and performance of detergents under harsh washing conditions [10, 11], the most frequently used approach has been to add at least one stabilization compound to a detergent formulation that includes an existing lipase as an ingredient [6]. This stabilization compound may be an organic or inorganic compound such as polyols, carboxylic acids, calcium salts, boron compounds etc. [6, 12]. Boron-based enzyme stabilization systems are typically used at levels from 0.01 to 10 %, preferably from 0.05 to 6.0 %, and more preferably from 0.1 to 3.0 % by weight of the composition [13].
In addition to acting as enzyme stabilizers, boron compounds are also known to control bacteria and fungi [14, 15]. Since the ability to provide not only a clean, but a hygienic environment is a desirable characteristic in a detergent [16], a wide variety of boron compounds are used in the production of laundry detergents, household and industrial cleaners and personal care products [17] to enhance stain removal and bleaching, stabilize enzymes, soften water, boost surfactant performance and provide alkaline buffering [18]. Whether in homes, industrial production or health-care, the failure to completely eradicate pathogenic microorganisms from textiles, food and beverage containers and surfaces despite washing [19, 20] can result in serious public health problems [16], and while a detergent may successfully remove soils and stains, this does not necessarily ensure the removal of pathogens. It has been suggested that if a detergent component used for lipase stabilization itself exhibits antimicrobial characteristics, the detergent will also demonstrate antimicrobial activity.
In this study, we describe the production, purification and characterization of a detergent-stable alkaline lipase produced by Pseudomonas aeruginosa ES3 isolated from kitchen wastewater. We also examine the effects of various boron compounds on enzyme stabilization with regards to pH, temperature, storage and commercial detergent formulations. Finally, we investigate the antimicrobial activities of various boron compounds used in enzyme stabilization.
Experimental
Screening and Isolation of Detergent Stable Lipolytic Microorganisms
Rhodamine-B agar medium (0.8 % nutrient broth (NB), 0.4 % NaCl, 2.5 % olive oil, 1 % agar and 1 ‰ Rhodamine B) was used for the initial screening of lipolytic microorganisms from various kitchen wastewater samples. The kitchen wastewater samples were inoculated and incubated for 24–48 h at 30 °C in this medium, and the lipolytic activity was screened under UV light. The appearance of an orange fluorescent zone around the bacterial colonies indicated the lipolytic activity [21].
After extensive screening of lipase producers, the isolates that exhibited lipase activity were then inoculated onto the Rhodamine-B agar medium containing commercial detergent (1 %) to determine their detergent stability [22].
Culture and Growth Conditions
Production of lipase by isolate was carried out in nutrient broth (NB). The medium was inoculated with a 2 % inoculum of an overnight culture and incubated at 30 °C at 130 rpm for 24 h. The culture medium was centrifuged at 10,000 rpm for 10 min at 4 °C and cell-free supernatant was used for the estimation of lipase activity.
Determination of Lipase Activity
Lipase activity was measured spectrophotometrically at 410 nm using p-nitrophenyl palmitate (p-NPP) as a substrate described by Winkler and Stuckmann [23] with some modifications [24]. One unit of enzyme activity was defined as the amount of enzyme that liberated 1 μmol/min of p-nitrophenol under standard assay conditions.
Determination of Detergent Stabilities of Lipases
The lipases of bacterial isolates were inoculated with commercial powder laundry and liquid detergents [Persil (Henkel, Austria) and Pril (Henkel, Austria)]. The detergents were diluted with tap water. Endogenous enzymes present in these detergents were inactivated by incubating the diluted detergent solutions at 100 °C for 1 h, prior to the addition of the lipase. The enzyme preparations were incubated with diluted detergents (final concentrations of 3 mg/mL and 3 µL/mL for powder and liquid detergents, respectively) for 1 h at 30 °C and the residual activity was determined at pH 8.0 and 30 °C. The enzyme activity of a control (without detergent) incubated under the similar conditions was taken as 100 %. The lipase exhibiting highest activity and stability toward the selected commercial detergents was selected for further experimentation.
Identification of Bacterial Strain
The isolate showing the highest activity and stability toward the selected commercial detergents was identified by 16S rRNA gene sequence analysis, using the bacterial universal primers 27F (5-AGA GTT TGA TCC TGG CTC AG-3) and 780-R (5-TAC CAG GGT ATC TAA TCC TGT T-3). Cycling parameters included initial denaturing for 2 min at 94 °C, 30 s at 94 °C, 30 cycles of 30 s at 53 °C, 40 s at 72 °C and a final 10-min extension step at 72 °C. Amplicons were then purified and sequenced outside of the laboratory in REFGEN (ODTU, Teknokent, Turkey). The sequence analysis was performed using the BLAST algorithm in Genbank (http://www.blast.ncbi.nlm.nih.gov). Bacterial identification was based on 16S rDNA gen sequence similarity.
Time Course of Lipase Production
The time course of lipase production of the strain was studied for 104 h. The inoculum was added [2 % (v/v)] to 250 mL NB in an Erlenmeyer flask and incubated at 130 rpm on a rotary shaker, at 30 °C. Samples were harvested periodically and bacterial growth, the pH of the culture medium, as well as the lipase activity in the culture supernatant were determined.
Purification of the Lipase
The cell-free supernatant (1000 mL) was precipitated by using ammonium sulfate at 60 % saturation. The precipitates were then harvested by centrifugation at 10,000 rpm for 30 min. The precipitate was dissolved in a minimal amount of buffer (50 mM Tris–HCl, pH 8.0) and dialyzed with a dialyzing membrane (Serva, Membra-Cel, MWCO 7.000) against 50 mM Tris–HCl buffer (pH 8.0) for 18 h. Then enzyme solution applied to a Sephacryl S100 HR (GE Healthcare) gel filtration column (ÄKTAprime™ plus) equilibrated with 50 mM Tris–HCl buffer (pH 8.0) at a flow rate of 4 mL/min. The elution fractions with the highest lipase activity were collected and then subjected to ultrafiltration using a centrifugal membrane filter (Millipore 5.000 MWCO). The fractions were monitored continuously at 280 nm for protein and also assayed individually for protein content [25] and lipase activity.
The molecular mass of the lipase was estimated by sodium dodecyl sulfate–polyacrylamide gel electrophoresis (SDS-PAGE). SDS-PAGE was performed with 16 % (w/v) SDS polyacrylamide gels by the method of Laemmli [26] at 200 V, 60 mA.
Characterization of Lipase
Effects of pH and Temperature on Lipase Activity
The pH activity profile of the lipase was measured by a p-NPP method in a pH range of 4.0–12.0 using different buffers at 50 mM concentration: phosphate-citrate buffer (pH 4.0–6.0), Tris–HCl buffer (pH 7.0–9.0) and glycine-NaOH buffer (pH 10.0–12.0). As p-NPP was unstable at pH above 9.0, the lipase activity was measured titrimetrically by using olive oil as the substrate at higher pH between 8.0 and 12.0. The reaction mixture was prepared by emulsifying 10 % (w/v) olive oil in 10 % (w/v) Triton X-100 in buffers with different pH values ranging between 8.0 and 12.0. A total of 1 mL of the crude lipase was added to each of the 10-mL reaction mixture at different pH and incubated for 30 min at 30 °C and 130 rpm in a shaker incubator. The reaction was stopped by adding 1 mL of 1:1 acetone/ethanol solution. Subsequently, 2–3 drops of phenolphthalein indicator were added to each of the reaction mixture. The contents of each reaction mixture were titrated with 0.05 M NaOH solution. The lipase activity was calculated as micromoles of free fatty acids formed from olive oil per mL of the crude lipase.
The effect of temperature on the activity of lipase was determined by monitoring the enzyme activity at various temperatures in the range of 10–60 °C at pH 9.0 (optimum pH) using p-NPP method. The optimum pH (9.0) and optimum temperature (40 °C) were used in the following studies.
Effects of Metal Ions and Enzyme Inhibitors on Lipase Stability
To determine the effect of various metal ions and enzyme inhibitors on lipase stability, the lipase was pre-incubated with the respective metal ions and enzyme inhibitors for 1 h at 30 °C, and then its residual activity was tested by the p-NPP method. The activity of the enzyme (without any additives) was taken as 100 %.
Effects of Surfactants and Oxidizing Agents on Lipase Stability
The effect of surfactants and oxidizing agents on the lipase stability was investigated by pre-incubating the lipase for 1 h at 30 °C in these agents. Then residual lipase activity was tested by the p-NPP method. The activity of the enzyme (without any additives) was taken as 100 %.
Effects of Commercial Detergents on Lipase Stability
The stability of the ES3 lipase in various commercial enzyme-containing powder/liquid detergents was investigated. The detergents utilized in this study were as follows: Ariel (Procter and Gamble, Belgium), Bingo (Hayat, Turkey), Bingo Color (Hayat, Turkey), Omo (Unilever, Turkey), Omo Color (Unilever, Turkey), Persil (Henkel, Austria), Persil Color (Henkel, Austria), Cif (Unilever, Turkey) and Pril (Henkel, Austria). The detergents were diluted in tap water to obtain a final concentration of 1 % to simulate washing conditions [27]. The endogenous enzyme present in these detergents was inactivated by incubating the diluted detergents at 100 °C for 1 h, prior to the addition of the lipase. The lipase was incubated with the diluted detergents for 1 h at 30 °C and the residual activity was determined at pH 9.0 at 40 °C. The enzyme activity of a control (without detergent) incubated under the similar conditions, was taken as 100 %. To allow further comparison, the effect of commercial detergents on the stability of Lipolase® was also studied under the same experimental conditions.
Effects of Boron Compounds on Lipase Stability
The effect of a variety of boron compounds (1.0–40.0 mM) on the enzyme activity was investigated by pre-incubating the lipase for 1 h at 30 °C in 50 mM Tris–HCl buffer (pH 8.0) containing the following boron compounds: potassium metaborate, boric acid, sodium metaborate and sodium tetraborate. The enzyme activity of the control (without boron compounds) incubated under the similar conditions, was taken as 100 %.
Lipase Stabilization
Effects of Boron Compounds on Lipase Inactivation by pH and Temperature
The effects of boron compounds on the stability of the lipase at pH between 9.0 and 12.0 were examined. The enzyme was pre-incubated in the presence or absence of potassium metaborate (5.0 mM), boric acid (5.0 mM), sodium metaborate (20.0 mM) or sodium tetraborate (20.0 mM) at various pH values for 1 h at 30 °C. The residual lipase activity was measured at 40 °C and pH 9.0 by using the p-NPP method. Initial lipase activity was taken as 100 %.
The effects of boron compounds on the temperature stability of lipase was determined by incubating the enzyme solution at different temperatures (30–60 °C) for 1 h in the presence or absence of potassium metaborate (5.0 mM), boric acid (5.0 mM), sodium metaborate (20.0 mM), or sodium tetraborate (20.0 mM). The residual lipase activity was measured at 40 °C, pH 9.0 by using the p-NPP method. Initial activity of the lipase was taken as 100 %.
Effects of Boron Compounds on Lipase Inactivation During Storage
The effects of boron compounds on the storage stability of the lipase were examined by incubating the lipase at 4 and 30 °C for 150 days in the absence or presence of boron compounds [potassium metaborate (5.0 mM), boric acid (5.0 mM), sodium metaborate (20.0 mM), or sodium tetraborate (20.0 mM)]. The residual activity was measured every 10 days with a standard enzyme assay. The initial lipase activity was considered 100 %.
Effects of Boron Compounds on Lipase Inactivation by Commercial Detergents
The effects of various boron compounds on the stabilization of the lipase added to commercial detergents were examined by incubating the enzyme with 1 % powder or liquid laundry detergents at 30 °C for 1 h in the presence of boron compounds [potassium metaborate (5.0 mM), boric acid (5.0 mM), sodium metaborate (20.0 mM), or sodium tetraborate (20.0 mM)]. The residual enzyme activity was measured at pH 9.0 and 40 °C. The enzyme activity of the control (without boron compounds) incubated under the similar conditions was taken as 100 %.
Antimicrobial Activity of Boron Compounds
The antibacterial and antifungal activities of the boron compounds were determined by the calculation of the minimal inhibitory concentration (MIC) and minimal bactericidal concentration (MBC) values. MIC and MBC assays were performed to determine the antimicrobial activity of the boron compounds against Pseudomonas aeruginosa ATCC 27853, Escherichia coli ATCC 25922, Staphylococcus aureus ATCC 25923, Bacillus subtilis ATCC 6633, Candida albicans ATCC 10239 and Aspergillus flavusby serial dilution of the test compounds.
Results and Discussion
The ability of enzymes to aid in the removal of stains and deliver other unique benefits that cannot otherwise be obtained with conventional technologies has long attracted the interest of the detergent industry. An ideal detergent enzyme should remain stable across a broad range of pH values and temperatures; be effective at low levels [28], and possess broad substrate specificity as well as compatibility with other detergent components such as surfactants, builders, bleaches and other enzymes, both during the washing process and in storage [29]. Unfortunately, enzyme activity is greatly reduced during storage, whether prior to its incorporation in the detergent product, or after the product has been purchased by the consumer [6]. This study investigated the purification, characterization and potential use of an alkaline lipase produced by P. aeruginosa ES3 isolated from kitchen wastewater as an environmentally friendly detergent additive. In addition, it examined the use of boron compounds in the stabilization of this lipase, and, given that clothes and dishes may acquire hygienic properties through washing in a detergent whose component(s) exhibit antimicrobial activities, this study also investigated the antimicrobial effects of the boron compounds used in enzyme stabilization.
Identification of the Microorganism
The 16S rDNA of strain ES3 was sequenced and then compared with other organisms in the NCBI database by BLAST analysis, the results of which suggested a close relationship between this ES3 strain and members of the Pseudomonas genus. Sequencing analysis was performed on approximately 760 bp PCR product. According to the phylogenetic trees based on the sequences of the 16S rRNA gene, strain ES3 was identified as P. aeruginosa (with 99 % homology) (Genbank accession number: KM270567).
Time Course of Lipase Production
Lipase activity was observed at the beginning of incubation and attained its maximum value (48.6 U/mL) at the end of the exponential phase, corresponding to 72 h of cultivation (data not shown). These results are in line with those for Pseudomonas sp. reported by Kiran et al. [30]. The pH of the culture medium increased gradually during growth, from an initial pH of 7.0–8.6 at the end of the incubation period (104 h). Similar results were reported by Yu et al. [31] for Pseudomonas Lip35 lipase culture medium.
Purification of the Lipase
The P. aeruginosa ES3 lipase was homogeneously purified using ammonium sulfate precipitation, gel filtration chromatography and ultrafiltration. The final lipase purification obtained was 36.19-fold, with a yield of 22.19 % (Table 1). Lipase purity was assessed by SDS-PAGE at each step of the purification process, and the molecular mass of the lipase was estimated to be approximately 40 kDa (Fig. 1).
Characterization of the Lipase
Effects of pH and Temperature on Lipase Activity
A pH activity profile of the P. aeruginosa ES3 lipase was developed by measuring enzyme activity at various pH values using both p-NPP and titration methods (Fig. 2a). The optimum pH for lipase activity was determined to be between 9.0 and 10.0, with relative activity of 75 % at pH 8.0 and 25 % at pH 11.0. Lipases, which are stable and active at alkaline pH (8–11), similar to the wash conditions of enzymatic powder and liquid detergents, have good potential for use in the detergent industry [32, 33].
With regard to temperature, the ES3 lipase was found to be active at temperatures ranging between 10 and 60 °C, with an optimum temperature of 40 °C (Fig. 2b) and relative activity of 74, 77 and 93 % at 10, 20 and 30 °C, respectively. The optimum temperature value is similar to values previously reported for other Pseudomonas sp. lipases [34, 35]. The high activity of the ES3 lipase at relatively low temperatures and high pH values suggests that its incorporation into detergent formulations would provide economic benefits to the industry.
Effects of Metal Ions and Enzyme Inhibitors on Lipase Stability
The effects of various metal ions on the activity of ES3 lipase were studied at pH 9.0/40 °C by adding cations to the reaction mixture at a final concentration of 5 mM (Table 2). Among the cations tested, only the addition of Ca2+ and Mn2+ resulted in an increase in lipase activity (by 127.5 and 102 %, respectively). The stimulatory effect of Ca2+ on lipase activity has been reported in other studies and has been attributed to structural alterations rather than any catalytic role [36, 37]. The present study also demonstrated that the enzyme was dramatically inactivated by Cu2+ and Cd2+, suggesting that these ions are able to operate directly at the site of catalyzation to alter enzyme conformation.
The effects of various enzyme inhibitors at concentrations of 0.1 % on lipase activity were assessed under standard conditions (Table 2). EDTA had no effect on the enzyme, whereas PMSF produced a slight reduction in enzyme activity. Iodoacetic acid had a significant inhibitory effect on enzyme activity, whereas β-mercaptoethanol had no effect on enzyme activity.
The enzyme was not affected by EDTA, demonstrating that the purified enzyme is not a metalloenzyme [38]. A slight reduction in the enzyme activity was observed in the presence of PMSF, indicating the presence of serin residues at the enzyme active site [39]. The iodoacetic acid had a significant inhibitory effect on lipase activity whereas β-mercaptoethanol did not affect the activity of the enzyme.
Effects of Surfactants and Oxidizing Agents on Lipase Stability
In order to be effective during washing, a good detergent lipase must be compatible with and be stable in the presence of all commonly used detergent components, such as surfactants, bleaches, oxidizing agents and other additives [5]. This study showed the ES3 lipase to be highly stable in the presence of strong anionic and non-ionic surfactants after 1 h of incubation at 30 °C (Table 2). In the presence of Tween 20, Tween 40, Tween 60, Tween 80, Triton X-100, saponin and SDS, respectively, the ES3 lipase retained 62.2, 100.2, 103.8, 78.4, 94.7, 93.5, 100.2 % of its initial activity.
The effects of oxidizing agents on the ES3 lipase varied. The lipase was quite stable in the presence of some oxidizing agents. Whereas 86.8 % of maximum lipase activity was retained in the presence of sodium hypochlorite, only 50.13 % was retained in the presence of sodium perborate, and in the presence of hydrogen peroxide, the lipase was deactivated, retaining only 7 % of its maximum activity (Table 2).
A previous study by Rathi et al. [27] reported that in the presence of sodium hypochlorite, sodium perborate and hydrogen peroxide, Lipolase® retained 43, 100 and 80 % of its activity respectively. Another study [37] examining the effects of sodium hypochlorite and hydrogen peroxide on Lipolase® activity reported similar values (46.3 and 82.5 %, respectively).
Effects of Commercial Detergents on Lipase Stability
The present study found the ES3 lipase to exhibit good stability against commercial detergents, making it a potential candidate in both liquid and solid detergent formulations (Table 3). In the presence of Omo, Bingo, Persil Color, Ariel and Pril, the ES3 lipase retained 100 % of its activity, and it was also highly stable in the presence of Omo Color (82.7 %) and Bingo Color (65.5 %), whereas Lipolase® retained only 37 % of its activity against Omo Color and only 42 % against Bingo Color. Moreover, a comparison between the results of the present study and those of previous studies shows the E3 lipase to be more stable than other lipases studied. For example, the recombinant Bacillus subtilis DR8806 lipase retained only about 95 % of its activity in the presence of Pril [40], the Fusarium solani N4-2 alkaline lipase retained only about 75 % of its activity in the presence of Omo and Ariel [37], and the Staphylococcus aureus SXL and SSL lipases retained 38 % and 25 % of their activities, respectively, in the presence of Ariel [22].
Effects of Boron Compounds on Lipase Stability
Table 4 shows the effects of different boron compounds in concentrations ranging from 1.0 to 40.0 mM on ES3 lipase stability. Whereas maximum lipase stability was achieved with 5 mM concentrations of potassium metaborate and boric acid (125 and 126 %, respectively), 20.0 mM concentrations of sodium metaborate and sodium tetraborate were required to obtain maximum lipase stability.
Lipase Stabilization
Effects of Boron Compounds on Lipase Inactivation by pH and Temperature
The enhancement of lipase stability by various boron compounds under different pH conditions ranging from 9.0 to 12.0 was examined (Fig. 3a), enzyme solutions were incubated for 1 h at 30 °C at pH values ranging from 9.0 to 12.0 alone and in the presence of 5.0 mM potassium metaborate, 5.0 mM boric acid, 20.0 mM sodium metaborate, or 20.0 mM sodium tetraborate. As shown in Fig. 3a, at pH 9.0, only boric acid was found to enhance the stability of the enzyme (by approximately 10 %), whereas at pH 12.0, all boron compounds tested contributed to enzyme stability (sodium tetraborate, 14.0 %; sodium metaborate, 13.3 %; potassium metaborate, 8.6 %; boric acid, 3 %).
Effects of boron compounds on the pH stability (a) and heat inactivation (b) of the lipase. The enzyme was pre-incubated in the absence (unfilled diamonds) or presence of potassium metaborate (filled triangles), boric acid (asterisks), sodium metaborate (filled squares), or sodium tetraborate (unfilled squares) at various pH values or different temperature for 1 h at 30 °C. The residual activity was measured at 40 °C, pH 9.0 by the method in lipase assay with p-NPP. Initial lipase activity was taken as 100 %. c The effects of boron compounds on storage stability of the lipase was examined by conserving the lipase at 4 °C (straight line) and 30 °C (dotted line) for 150 days in the absence (filled diamonds) or presence of potassium metaborate (unfilled triangles), boric acid (asterisks), sodium metaborate (filled squares), or sodium tetraborate (crosses). The residual activity was measured every 10 days with standard enzyme assay. Initial lipase activity was taken as 100 %
In order to understand the effects of boron compounds on ES3 lipase thermostability, enzyme solutions were incubated for 1 h at temperatures ranging from 30 to 60 °C alone and in the presence of 5.0 mM potassium metaborate, 5.0 mM boric acid, 20.0 mM sodium metaborate, or 20.0 mM sodium tetraborate (Fig. 3b). After 1 h incubation at 50 °C, the amount of activity retained by the ES3 lipase increased from 47 % when incubated alone to 56.4 % when incubated with sodium tetraborate and to 72.7 % when incubated with boric acid; after 1 h incubation at 60 °C, the amount of activity retained by the ES3 lipase increased from 38 % when incubated alone to 45.7 % when incubated with boric acid.
Lipases for detergents are specifically selected on the basis of stability under alkaline conditions (pH 10–11), at 30–60 °C and in the presence of surfactants [41]. Our results showed that boron components provide enzyme stability and that the ES3 lipase possesses the properties required for use as a detergent ingredient.
Effects of Boron Compounds on Lipase Inactivation During Storage
The amounts of enzymes included in liquid enzymatic compositions such as detergents may be increased in order to compensate for loss of enzyme activity during periods of storage [12]; however, because enzymes are relatively expensive ingredients [42], including enzyme stabilizers such as boron in liquid compositions may be preferable [43].
In the present study, the storage stability of the ES3 lipase was examined by incubating the enzyme preparation at 4 and 30 °C with or without boron compounds and measuring the residual enzyme activity at regular time intervals (Fig. 3c). At 10 days, the enzyme retained 100 % of its activity following incubation with or without boron at both temperatures. However, at 90 days, the enzyme retained only 73 % of its activity when incubated alone at 4 °C. A similar level of activity was observed with the addition of sodium metaborate (73.4 %), whereas the enzyme retained 98 % of its activity with the addition of boric acid and only 60 and 51.7 %, respectively, with the addition of potassium metaborate and sodium tetraborate. At 30 °C, the enzyme retained 80 % of its activity when incubated alone, and 76.6, 74, 70.8 and 67 %, respectively, when incubated with boric acid, sodium tetraborate, potassium metaborate and sodium metaborate.
A previous study reported that potassium borate increased the storage stability of the enzyme [44]. Similarly, boric acid has been shown to increase the storage stability of Lipolase®at 35 °C [12].
Effects of Boron Compounds on Lipase Inactivation by Commercial Detergents
In order to understand how the inclusion of boron compounds affects ES3 lipase activity in the presence of commercial detergents, enzyme solutions were incubated for 1 h at 30 °C at pH values in the presence of either Bingo Color, Persil Color, Ariel, Pril, or Cif, alone or in combination with 5.0 mM potassium metaborate, 5.0 mM boric acid, 20.0 mM sodium metaborate, or 20.0 mM sodium tetraborate. As shown in Fig. 4, the presence of sodium tetraborate increased the stability of the lipase against Bingo Color, Persil Color, Ariel, Pril and Cif by 41.7, 46, 23, 8.5 and 9 %, respectively; the addition of sodium metaborate increased the stability of the lipase against Bingo, Bingo Color, Persil Color, Ariel and Cif by 15, 40.5, 52, 19 and 6 %, respectively; and the addition of boric acid increased the stability of the lipase against Omo Color, Bingo Color, Persil, Persil Color and Cif by 2.5, 18, 4.6, 8 and 3.6 %, respectively.
Antimicrobial Activity of Boron Compounds
All boron compounds tested showed antibacterial activity against P. aeruginosa ATCC 27853, E. coli ATCC 25922, S. aureus ATCC 25923 and B. subtilis ATCC 6633 in vitro (Table 5). Of the various compounds tested, boric acid and sodium tetraborate showed a similar bactericidal activity against P. aeruginosa ATCC 27853, E. coli ATCC 25922, S. aureus ATCC 25923. Previous studies have similarly reported boron compounds to exhibit antimicrobial activity against a variety of microorganisms, including S. aureus, P. aeruginosa, B. subtilis, E. coli, C. albicans, Candida glabrata and Saccharomyces cerevisiae [14, 15, 45, 46].
All boron compounds tested also showed antifungal activity against C. albicans ATCC 10239 and A. flavus, with sodium metaborate, potassium metaborate and sodium tetraborate showed a similar antifungal activity against C. albicans ATCC 10239. In addition, sodium metaborate and sodium tetraborate exhibited the highest degree of antifungal activity against A. flavus as compared with other boron compounds.
Conclusion
This study aimed to produce, purify and characterize a lipase obtained from a bacterium isolated from kitchen wastewater for use as a detergent ingredient. The findings suggest that the ES3 lipase obtained from P. aeruginosa could represent an important detergent additive due its activity at low temperatures and high pHs as well as its stability in the presence of surfactants, oxidizing agents and commercial detergents. The addition of various boron compounds was shown to increase the stability of the lipase as well as its activity in alkaline pH environments, high temperatures and in combination with commercial detergent formulations containing surfactants and oxidants. Furthermore, the boron compounds used to stabilize the lipase were found to possess antimicrobial properties, suggesting that detergents incorporating these compounds will also exhibit antimicrobial activity when washing clothes and dishes.
References
Houde A, Kademi A, Leblanc D (2004) Lipases and their industrial applications. Appl Biochem Biotechnol 118:115–170
Aehle W (2007) Enzymes in industry, production and applications, 3rd edn. Wiley-VCH, Weinheim
Joseph B, Ramteke PW, Thomas G (2008) Cold active microbial lipases: some hot issues and recent developments. Biotechnol Adv 26:457–470
Gormsen E, Marcussen E, Damhus T (1998) In: Showell MS (ed) Enzymes. in: Powdered detergents, Surfactant Science Series. Marcel Dekker, New York, pp 137–165
Hemachander C, Puvanakrishnan R (2000) Lipase from Ralstonia pickettii as an additive in laundry detergent formulations. Process Biochem 35:809–814
Jain M (2008) Enzymology, Assignment-1. Enzymes used in detergents, Amity Institute of Biotechnology, Noida, pp 22. http://www.scribd.com/doc/11523933/Enzymes-in-Detergents
Jurado E, Bravo V, Núñez-Olea J, Bailón R, Altmajer-Vaz D, García-Román M et al (2006) Enzyme-based detergent formulas for fatty soils and hard surfaces in a continuous-flow device. J Surfactants Deterg 9:83–90
Jaouadi B, Ellouz-Chaabouni S, Rhimi M, Bejar S (2008) Biochemical and molecular characterization of a detergent-stable serine alkaline protease from Bacillus pumilus CBS with high catalytic efficiency. Biochimie 90:1291–1305
Romdhane IBB, Fendri A, Gargouri Y, Gargouri A, Belghith H (2010) Novel thermoactive and alkaline lipase from Talaromyces thermophilus fungus for use in laundry detergents. Biochem Eng J 53:112–120
Joo HS, Koo YM, Choi JW, Chang CS (2005) Stabilization method of an alkaline protease from inactivation by heat, SDS and hydrogen peroxide. Enzyme Microb Technol 36:766–772
Sugimura Y, Fukunaga K, Matsuno T, Nakao K, Goto M, Nakashio F (2000) A study on the surface hydrophobicity of lipases. Biochem Eng J5:123–128
Lenoir PM (2011) Enzyme stabilization US Patent 7928052 B2
Delplancke PFA, Boutique J, Scialla S, Sivik MR, Kluesener BW, Wang J (2007) Liquid laundry detergent composition containing boron-compatible cationic deposition aids. United States Patent 7226900
van Waasbergen LG, Fajdetic I, Fianchini M, Rasika Dias HV (2007) Antimicrobial properties of highly fluorinated tris(pyrazolyl)borates. J Inorg Biochem 101:1180–1183
Cencetti C, Bellini D, Pavesio A, Senigaglia D, Passariello C, Virga A et al (2012) Preparation and characterization of antimicrobial wound dressings based on silver, gellan, PVA and borax. Carbohydr Polym 90(3):1362–1370
Borates in detergency. http://www.borax.com/detergents/sanitization.html. Accessed Oct 2014
Roskill (2002) The economics of Boron, 10th edn. Roskill Information Services, London
Borates in detergency. http://www.borax.com/market/detergents.aspx. Accessed Aug 2014
Orr KE, Holliday MG, Jones AL, Robson I, Perry JD (2002) Survival of enterococci during hospital laundry processing. J Hosp Infect 50:133–139
Fijan S, Turk SS (2012) Hospital textiles, are they a possible vehicle for healthcare-associated infections? Int J Environ Res Public Health 9:3330–3343
Haba E, Bresko O, Ferrer C, Marqués A, Busquets M, Manresa A (2000) Isolation of lipase-secreting bacteria by deploying selective substrate. Enzyme Microb Technol 6:40–44
Horchani H, Mosbah H, Salem NB, Gargouri Y, Sayari A (2009) Biochemical and molecular characterisation of a thermoactive, alkaline and detergent-stable lipase from a newly isolated Staphylococcus aureus strain. J Mol Catal B 56:237–245
Winkler UK, Stuckmann M (1979) Glycogen, hyaluronate, and some other polysaccharides greatly enhance the formation of exolipase by Serratia marcescens. J Bacteriol 138:663–670
Boran R, Ugur A (2010) Partial purification and characterization of the organic solvent tolerant lipase produced by Pseudomonas fluorescens RB02-3 isolated from milk. Prep Biochem Biotechnol 40:229–241
Bradford MM (1976) A rapid and sensitive for the quantitation of microgram quantities of protein utilizing the principle of protein-dye binding. Anal Biochem 72:248–254
Laemmli UK (1970) Cleavage of structural proteins during the assembly of the head of bacteriophage T4. Nature (London) 227:680–685
Rathi P, Saxena RK, Gupta R (2001) A novel alkaline lipase from Burkholderia cepacia for detergent formulation. Process Biochem 37:187–192
Kumar CG, Malik RK, Tiwari MP (1998) Novel enzyme-based detergents: an Indian perspective. Curr Sci 75:1312–1318
Smulders E, Rashe W, Von Rybinski W, Stbeer J, Sung E, Wiebel F (2002) Detergent ingredients. In: Smulders E (ed) Laundry detergents. Wiley, Weinheim, pp 38–98
Kiran GS, Shanmughapriya S, Jayalakshmi J, Selvin J, Gandhimathi R, Sivaramakrishnan S et al. (2008) Optimization of extracellular psychrophilic alkaline lipase produced by marine Pseudomonas sp. (MSI057). Bioprocess Biosyst Eng 31:483–492
Yu H, Han J, Li N, Qie X, Jia Y (2009) Fermentation performance and characterization of cold adapted lipase produced with Pseudomonas Lip35. Agric Sci China 8:956–962
Jaeger KE, Ransac S, Dijkstra BW, Colson C, Heuvel M, Misset O (1994) Bacterial lipases. FEMS Microbiol Rev 15:29–63
Hasan F, Shah AA, Hameed A (2006) Industrial applications of microbial lipases. Enzyme Microbiol Technol 39:235–251
Lin SF, Chiou CM, Yeh CM, Tsai YC (1996) Purification and partial characterization of an alkaline lipase from Pseudomonas pseudoalcaligenes F-111. Appl Environ Microbiol 62:1093–1095
Ji Q, Xiao S, He B, Liu X (2010) Purification and characterization of an organic solvent-tolerant lipase from Pseudomonas aeruginosa LX1 and its application for biodiesel production. J Mol Catal B 66:264–269
Dandavate V, Jinjala J, Keharia H, Madamwar D (2009) Production, partial purification and characterization of organic solvent tolerant lipase from Burkholderia multivorans V2 and its application for ester synthesis. Bioresour Technol 100:3374–3381
Liu R, Jiang X, Mou H, Guan H, Hwang HM, Li X (2009) A novel low-temperature resistant alkaline lipase from a soda lake fungus strain Fusarium solani N4-2 for detergent formulation. Biochem Eng J 46:265–270
Ramirez-Zavala B, Mercado-Flores Y, Hernadez-Rodriguez C, Villa-Tanaca L (2004) Purification and characterization of lysine aminopeptidase from Kluyveromyces marxiamus. FEMS Microbiol Lett 235:369–375
George V, Diwan AM (1983) Simultaneous staining of proteins during polyacrylamide gel electrophoresis in acidic gels by countermigration of Coomassie brilliant blue R-250. Anal Biochem 132:481–483
Emtenani S, Asoodeha A, Emtenani S (2013) Molecular cloning of a thermo-alkaliphilic lipase from Bacillus subtilis DR8806: expression and biochemical characterization. Process Biochem 48:1679–1685
Hasan F, Shah AA, Javed S, Hameed A (2010) Enzymes used in detergents: lipases. AJB 9(31):4836–4844
Man VFP, Lentsch SE, Killeen YM (2003) Stable liquid enzyme compositions with enhanced activity. US Patent 6624132 B1
Russell SW (1992) Storage-stable enzymatic liquid detergent composition. US Patent 5124066 A
Lentsch SE, Man VF, McBroom AB, Peitersen ND, Ruhr RO, Schacht PF, Tilleskjor J (2009) Stable liquid enzyme compositions. US Patent 7569532 B2
De Seta F, Schmidt M, Vu B, Essmann M, Larsen B (2009) Antifungal mechanisms supporting boric acid therapy of Candida vaginitis. J Antimicrob Chemoth 63:325–336
Bursali EA, Coskun S, Kizil M, Yurdakoc M (2011) Synthesis, characterization and in vitro antimicrobial activities of boron/starch/polyvinyl alcohol hydrogels. Carbohydr Polym 83:1377–1383
Acknowledgments
This work was supported by TUBITAK, The Scientific and Technical Research Council of Turkey, through the Grant number TBAG- 210T084.
Author information
Authors and Affiliations
Corresponding author
About this article
Cite this article
Sarac, N., Ugur, A., Boran, R. et al. The Use of Boron Compounds for Stabilization of Lipase from Pseudomonas aeruginosa ES3 for the Detergent Industry. J Surfact Deterg 18, 275–285 (2015). https://doi.org/10.1007/s11743-014-1653-7
Received:
Accepted:
Published:
Issue Date:
DOI: https://doi.org/10.1007/s11743-014-1653-7